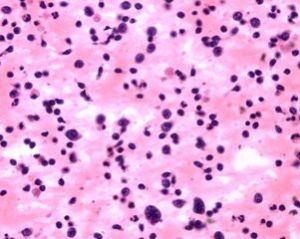
紫癜

與西醫病關係
本病包括西醫學的過敏性紫癜和血小板減少性紫癜。紫癜是皮膚和黏膜出血後顏色改變的總稱。臨床表現為出血點、紫癜和瘀斑,一般不高出皮面,僅於過敏性紫癜時可稍隆起,開始為紫紅色,壓不退色,以後逐漸變淺,至兩周左右變黃而消退。病因
紫癜以病在血分為主,有虛實之分。外因為外感風熱之邪,濕熱挾毒蘊阻於肌表血分,迫血妄行,外溢皮膚孔竅,以實證為主。內因為素體心脾氣血不足,腎陰虧損,虛火上炎,血不歸經所致,以虛證為主。病機
 紫癜
紫癜若小兒先天稟賦不足,或疾病遷延日久,耗氣傷陰,均可致氣虛陰傷,病情由實轉虛,或虛實夾雜。氣虛則統攝無權,氣不攝血,血液不循常道而溢於脈外;陰虛火炎,血隨火動,滲於脈外,均可致紫癜反覆發作。
臨床診斷
診斷要點
 紫癜
紫癜鑑別診斷
應注意鑑別本病是過敏性紫癜還是血小板減少性紫癜。1.過敏性紫癜發病前可有上呼吸道感染或服食某些藥物、食物等誘因。紫癜多見於下肢伸側及臀部、關節周圍。為高出皮膚的鮮紅色至深紅色丘疹、紅斑或蕁麻疹,大小不一,多呈對稱性,分批出現,壓之不退色。可伴有腹痛、嘔吐、血便等消化道症狀,遊走性大關節腫痛及血尿、蛋白尿等。血小板計數,出血、凝血時間,血塊收縮時間均正常。應注意定期複查尿常規,常有鏡下血尿、蛋白尿。
2.血小板減少性紫癜皮膚黏膜見瘀點、瘀斑。瘀點多為針頭樣大小,一般不高出皮面,多不對稱,可遍及全身,但以四肢及頭面部多見。可伴有鼻衄、齒衄、尿血、便血等。嚴重者可並發顱內出血。血小板計數明顯減少,急性型一般低於20乘以10的9次/L,慢性型一般在30x10的9次/L-80X10的9次/L之間。出血時間延長,血塊收縮不良,束臂試驗陽性。
辯證論治
辨證要點
 紫癜
紫癜要注意判斷病情的輕重。以出血量的多少及是否伴有腎臟損害或顱內出血等作為判斷輕重的依據。凡出血量較少者為輕症;出血嚴重伴大量便血、血尿、明顯蛋白尿,或頭痛、昏迷、抽搐等均為重症。
治療原則
本病的治療,實證以清熱涼血為主;虛證以益氣攝血、滋陰降火為主。臨證須注意證型之間的相互轉化或同時並見。治療時宜分清主次,統籌兼顧。分證論治
1.風熱傷絡證候:起病較急,全身皮膚紫癜散發,尤以下肢及臀部居多,呈對稱分布,色澤鮮紅,大小不一,或伴癢感,可有發熱、腹痛、關節腫痛、尿血等,舌質紅,苔薄黃,脈浮數。
治法:疏風散邪。
方藥:連翹敗毒散加減。
常用藥:薄荷、防風、牛蒡子、連翹、山梔、黃芩、升麻、玄參、桔梗、當歸、赤芍、紅花。
2.血熱妄行
證候:起病較急,皮膚出現瘀點瘀斑,色澤鮮紅,或伴鼻衄、齒衄、嘔血、便血、尿血,血色鮮紅或紫紅。同時並見心煩、口渴、便秘,或伴腹痛,或有發熱,舌紅,脈數有力。
治法:清熱解毒,涼血止血。
方藥:犀角地黃湯加味。
常用藥:犀角(用水牛角代)、生地、丹皮、赤芍、紫草、玄參、黃芩、生甘草。
3.氣不攝血
 紫癜
紫癜治法:健脾養心,益氣攝血。
方藥:歸脾湯加減。
常用藥:黨參、白朮、茯苓、甘草、黃芪、當歸、遠志、酸棗仁、龍眼肉、木香、生薑、大棗。
4.陰虛火炎
證候:紫癜時發時止,鼻衄齒衄,血色鮮紅,低熱盜汗,心煩少寐,大便乾燥,小便黃赤,舌光紅,苔少,脈細數。
治法:滋陰降火,涼血止血。
方藥:大補陰丸加減。
常用藥:熟地、龜板、黃柏、知母、豬脊髓、蜂蜜。
其他療法
針灸療法
1.主穴:曲池、足三里。備穴:合谷、血海。先刺主穴,效果不好加刺備穴。有腹痛加刺三陰交、太沖、內關。用於過敏性紫癜。2.取穴八遼、腰陽關。艾柱隔姜灸。每穴灸45分鐘,1日1次。用於氣不攝血證。
3.先針膈俞、脾俞,呈45°角向脊柱方向斜刺,快速進針,捻轉提插,得氣後留針5分鐘,繼針血海、三陰交,直刺得氣後留針30分鐘。1日1次,半個月為1療程。用於氣不攝血證和陰虛火炎證。
預防調護
預防
紫癜
紫癜2.過敏性紫癜要儘可能找出引發的各種原因。積極防治上呼吸道感染,控制扁桃體炎、齲齒、鼻竇炎,驅除體內各種寄生蟲,不吃容易引起過敏的飲食及藥物。
3.對血小板減少性紫癜,要注意預防呼吸道感染、麻疹、水痘、風疹及肝炎等疾病,否則易於誘發或加重病情。
護理
1.急性期或出血量多時,要臥床休息,限制患兒活動,消除其恐懼緊張心理。2.避免外傷跌仆碰撞,以免引起出血。
3.血小板計數低於20x10的9次/L時,要密切觀察病情變化,防止各種創傷與顱內出血。
4.飲食宜清淡,富於營養,易於消化。嘔血、便血者應進半流飲食,忌硬食及粗纖維食物。忌辛辣刺激食物。血小板減少性紫癜患兒子素可多吃帶衣花生仁、紅棗等食物。
文獻記載
《諸病源候論·小兒雜病諸候·患斑毒病候》:“斑毒之病,是熱氣入胃,而胃主肌肉,是熱挾毒蘊積於胃,毒氣熏發於肌肉,狀如蚊蚤所齧,赤斑起,周匝遍體。”《證治準繩·瘍醫》:“夫紫癜風者,由皮膚生紫點,搔之皮起,而不癢痛者是也。此皆風濕邪氣客於腠理,與氣血相搏,致營衛否澀,風冷在於肌肉之間,故令色紫也。”

